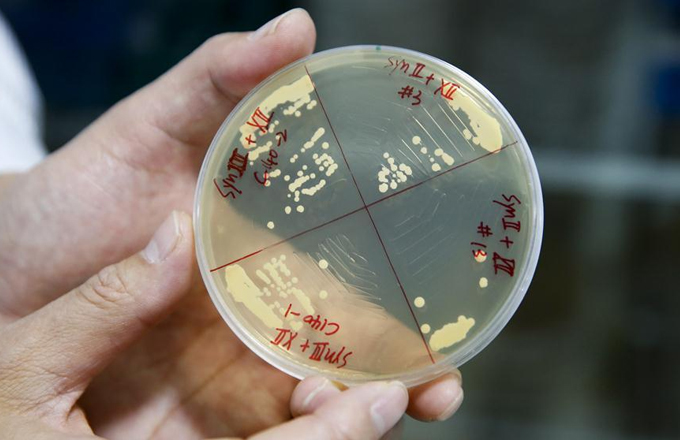

National People's Congress holds press conference on supervisory work
 |
|
Liu Binjie, chairman of the Education, Science, Culture and Public Health Committee of the 12th National People's Congress, Wang Shengming, vice-chairperson of the Internal and Judicial Affairs Committee of the 12th National People's Congress, Yin Zhongqing, vice-chairperson of the Financial and Economic Affairs Committee of the 12th National People's Congress, Yuan Si, vice-chairman of the Environment Protection and Resources Conservation Committee of the 12th National People's Congress, Liu Xiuwen, vice-chairman of the Budgetary Affairs Commission of the NPC Standing Committee and Fu Wenjie, inspector of the Bureau of Secretaries of the NPC Standing Committee, take questions on the NPC's supervisory work for the fifth session of the 12th NPC at a press conference in Beijing on March 10, 2017. [Photo by Feng Yongbin/China Daily] |